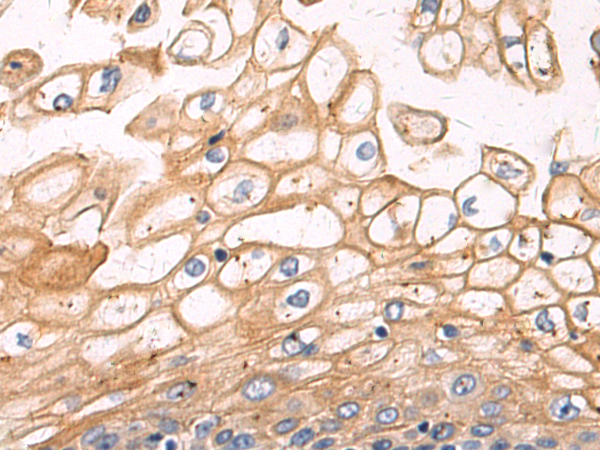
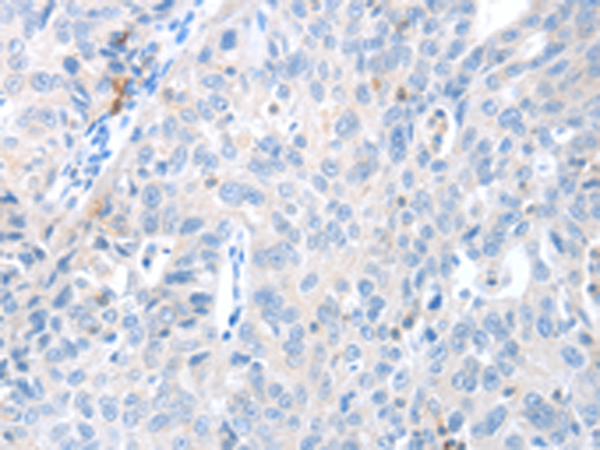
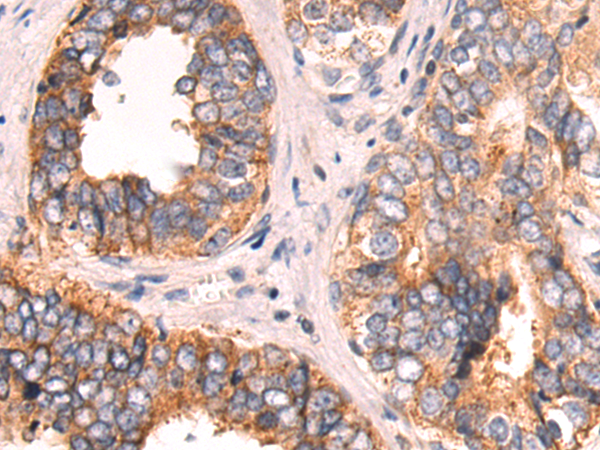
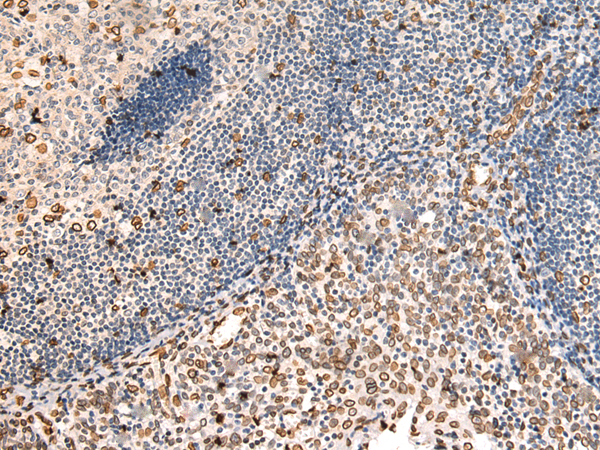

-
分类: 科研抗体货号: P00517别名: MEK6, MKK6, MAPKK6, PRKMK6, SAPKK3, SAPKK-3应用: WB,IHC反应种属: Human, Mouse
-
分类: 科研抗体货号: P00446别名: GRDF; IGF-II; PP9974; C11orf43应用: WB反应种属: Human, Mouse, Rat
-
分类: 科研抗体货号: P00583别名: BLCPMG; PTORCH1; PPP1R115应用: WB,IHC反应种属: Human, Mouse, Rat
-
分类: 科研抗体货号: P00514别名: CT3.6应用: WB,IHC反应种属: Human
-
分类: 科研抗体货号: P00445别名: IMP2; IMP-2; VICKZ2应用: WB,IHC反应种属: Human, Mouse
-
分类: 科研抗体货号: P00510别名: MAD1; PIG9; TP53I9; TXBP181应用: WB反应种属: Human, Mouse
-
分类: 科研抗体货号: P00581别名:应用: WB,IHC反应种属: Human, Mouse
-
分类: 科研抗体货号: P00443别名: IFG; IFI应用: IHC反应种属: Human
-
分类: 科研抗体货号: P00503别名: FPL; IDC; LFP; CDDC; EMD2; FPLD; HGPS; LDP1; LMN1; LMNC; MADA; PRO1; CDCD1; CMD1A; FPLD2; LMNL1; CMT2B1; LGMD1B应用: WB,IHC反应种属: Human, Mouse, Rat
-
分类: 科研抗体货号: P00572别名: NM23H5; RSPH23; NM23-H5应用: IHC反应种属: Human, Mouse

鄂公网安备42018502007531号
鄂公网安备42018502007531号

